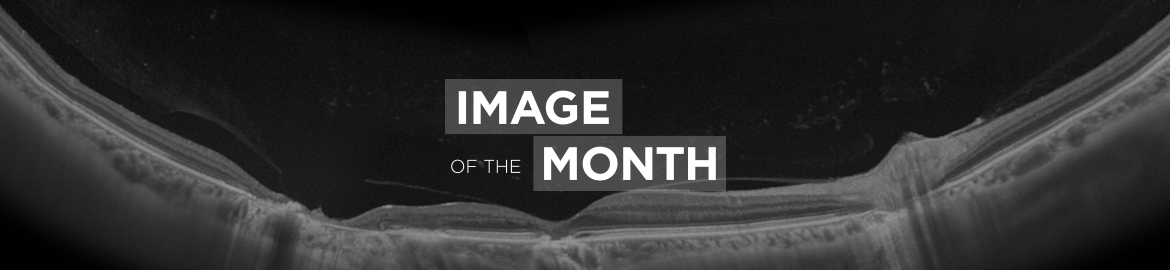

IOTM: Toxoplasmosis Retinochoroiditis
Image of the Month (IOTM) is a collection of interesting clinical cases with high quality images for all relevant imaging modalities (ex: color fundus, OCT, OCTA, FAF, FA, En Face, Red-free, choroidal vasculography (CVG), anterior imaging) and other clinical results if relevant (ex: visual field plots). Each case is submitted by an eye care professional using one of Topcon’s industry-leading OCT devices.
Case background
A 57-year-old Indian female with a prior history of posterior uveitis was referred for scarring OD. BCVA 20/20 OU, diagnostic testing demonstrated +IgG antibodies to toxoplasmosis, IgM was negative. Upon further questioning, the patient did report a prior history of eating uncooked pork. Color Fundus photograph of the right eye (Image A) demonstrated several extrafoveal pigmented chorioretinal atrophy lesions. Enface Swept-Source OD (Image B) demonstrated several chorioretinal lesions. OCT B-scan of the macula (Image C) demonstrated outer retinal, ellipsoid zone, RPE, and atrophy of the choriocapillaris. 24mm posterior pole structural B-scan OCT (Image D) revealed two regions of retinal atrophy.
— Netan Choudhry, MD FRCS(C) FASRS
Diagnosis: Toxoplasmosis Retinochoroiditis
Captured with: Topcon DRI OCT Triton Swept-Source
DRI OCT Triton Images:
A. Color Fundus Image
B. Enface Swept-Source OCT Image
C. OCT B-Scan of the Macula
D. OCT B-Scan
The opinions, ideas, views and assumptions expressed are the author’s own and do not necessarily represent the views of Topcon, nor do they constitute advice from Topcon.






